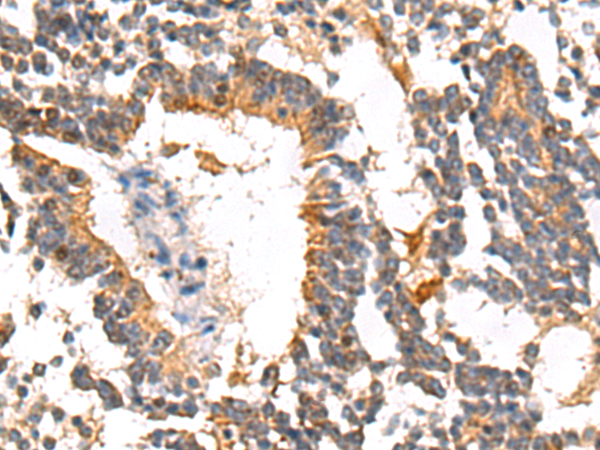
一抗

中文名稱: 兔抗SERPINB7多克隆抗體
英文名稱: Anti-SERPINB7 rabbit polyclonal antibody
別 名:serpin family B member 7; PPKN; TP55; MEGSIN
相關(guān)類別: 一抗
儲 存: 冷凍(-20℃)
宿 主: Rabbit
抗 原: SERPINB7
反應(yīng)種屬: Human
標(biāo) 記 物: Unconjugate
克隆類型: rabbit polyclonal
技術(shù)規(guī)格
|
Background: |
This gene encodes a member of a family of proteins which function as protease inhibitors. Expression of this gene is upregulated in IgA nephropathy and mutations have been found to cause palmoplantar keratoderma, Nagashima type. Alternative splicing results in multiple transcript variants. |
|
Applications: |
ELISA, WB, IHC |
|
Name of antibody: |
SERPINB7 |
|
Immunogen: |
Synthetic peptide of human SERPINB7 |
|
Full name: |
serpin family B member 7 |
|
Synonyms: |
PPKN; TP55; MEGSIN |
|
SwissProt: |
O75635 |
|
ELISA Recommended dilution: |
5000-10000 |
|
IHC positive control: |
Human liver cancer |
|
IHC Recommend dilution: |
50-200 |
|
WB Predicted band size: |
43 kDa |
|
WB Positive control: |
HL60 cell lysate |
|
WB Recommended dilution: |
500-2000 |


 購物車
購物車 幫助
幫助
 021-54845833/15800441009
021-54845833/15800441009